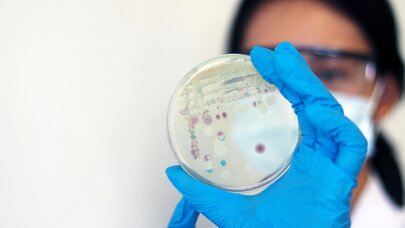

İdman
Avropa çempionu karyerasını başa vurdu

“Lester” və Portuqaliya millisinin sabiq yarımmüdafiəçisi Adriyen Silva karyerasını başa vurduğunu açıqlayıb.
Publika.az xəbər verir ki, butbolçu bununla bağlı sosial şəbəkə hesablarında paylaşım edib.
Vida məktubunda Silva bütün komanda yoldaşlarına, məşqçilərə və azarkeşlərə təşəkkürünü bildirib, xüsusi olaraq 2016-cı il Avropa Çempionatında qazanılan qələbəni xatırlayıb.
Klub səviyyəsində o, “Lester”, “Sportinq”, “Monako”, “Riu Ave”, “Makkabi Hayfa”, “Sampdoriya” və Səudiyyə Ərəbistanından iki komanda – “Əl-Vahda” və “FC United”də çıxış edib.
“Sportinq” ilə Silva iki dəfə Portuqaliya Kubokunu, üç dəfə isə Superkuboku qazanıb. Portuqaliya millisində yarımmüdafiəçi 26 oyun keçirib, 1 qol vurub və Avropa çempionu olub.
-
 Magazin105:15
Magazin105:15Samirə Efendi jüri kürsüsündə huşunu itirdi: səhnədən belə apardılar - VİDEO
-
 Qoroskop02:19
Qoroskop02:19Günün ulduz falı: intuisiyanız pik nöqtədədir...
-
 Avropa01:40
Avropa01:40Fransada yeni hökumət quruldu
-
 Magazin112 Oktyabr 22:44
Magazin112 Oktyabr 22:44Namiq ilk dəfə xanımı ilə şəklini paylaşdı, üzünü gizlətdi
-
 Ekologiya12 Oktyabr 20:32
Ekologiya12 Oktyabr 20:32Günəşdə güclü partlayışlar olacaq
-
 İdman12 Oktyabr 20:20
İdman12 Oktyabr 20:20Messi MLS tarixində bunu bacaran ilk futbolçu oldu
-
 Ekopublika.az12 Oktyabr 19:19
Ekopublika.az12 Oktyabr 19:19Trampın nə qədər "Bitcoin"i var? - "Forbes" açıqladı
-
.jpg) Ekologiya12 Oktyabr 18:29
Ekologiya12 Oktyabr 18:29Əhaliyə xəbərdarlıq: oktyabrın 13-də...










.jpg)

.jpg)












